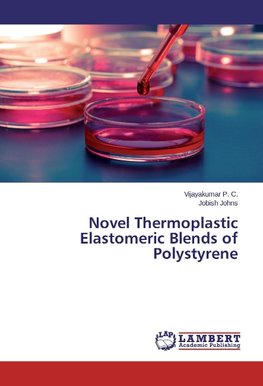
Novel Thermoplastic Elastomeric Blends of Polystyrene

-
 Anglický jazyk
Anglický jazyk
Novel Thermoplastic Elastomeric Blends of Polystyrene
Autor: Vijayakumar P. C.
Thermoplastic elastomeric blends of Polystyrene (PS) and Exudated Resin (ER) are prepared by solution casting technique. The nature of solvent diffusion through the prepared blends of Exudated Resin and Polystyrene of different compositions are studied at... Viac o knihe
Na objednávku, dodanie 2-4 týždne
53.68 €
bežná cena: 56.50 €
O knihe
Thermoplastic elastomeric blends of Polystyrene (PS) and Exudated Resin (ER) are prepared by solution casting technique. The nature of solvent diffusion through the prepared blends of Exudated Resin and Polystyrene of different compositions are studied at various temperatures. Swelling experiment has been conducted in benzene as the solvent to investigate the solvent resistance properties of these blends. The important parameters such as diffusion, sorption and permeation coefficients are calculated and the effect of blend ratio on these parameters is also studied. The activation energies of diffusion are estimated from the sorption data. An anomalous behavior is observed for most of the blend compositions. Thermogravimetric analysis was employed to determine the decomposition behavior of these blends. The dependence of blend composition and cross-linking on the thermal behavior of ER/PS blend system was studied. It is observed that the addition of exudated resin into polystyrene improves the thermal stability. X-ray diffraction technique was employed to study the crystalline nature of the blend system.Resin can be effectively used to reduce the brittleness of polystyrene.
- Vydavateľstvo: LAP LAMBERT Academic Publishing
- Rok vydania: 2015
- Formát: Paperback
- Rozmer: 220 x 150 mm
- Jazyk: Anglický jazyk
- ISBN: 9783659596773








 Nemecký jazyk
Nemecký jazyk 


